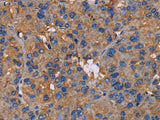
NCSTN Polyclonal Antibody Store at -20°C, Biomarkers, Elabscience Biotechnology, MSE Supplies

NCSTN Polyclonal Antibody Store at -20°C
SKU: E-AB-15254-200
NCSTN Polyclonal Antibody Store at -20°C
| SKU # | E-AB-15254 |
| Reactivity | Human, Mouse, Rat |
| Host | Rabbit |
| Applications | IHC |
Product Details
| Isotype | IgG |
| Host | Rabbit |
| Reactivity | Human, Mouse, Rat |
| Applications | IHC |
| Clonality | Polyclonal |
| Immunogen | Recombinant protein of human NCSTN |
| Abbre | NCSTN |
| Synonyms | APH 2, APH2, ATAG1874, Anterior pharynx defective 2, KIAA0253, NCT, NICA, Ncstn, Nicastrin, RP11 517F10.1, RP11517F101 |
| Swissprot | |
| Cellular Localization | Membrane. Melanosome. Identified by mass spectrometry in melanosome fractions from stage I to stage IV. |
| Concentration | 0.4 mg/mL |
| Buffer | Phosphate buffered solution, pH 7.4, containing 0.05% stabilizer and 50% glycerol. |
| Purification Method | Affinity purification |
| Research Areas | Cancer, Neuroscience, Stem Cells |
| Conjugation | Unconjugated |
| Storage | Store at -20°C Valid for 12 months. Avoid freeze / thaw cycles. |
| Shipping | The product is shipped with ice pack,upon receipt,store it immediately at the temperature recommended. |
Related Reagents
| Applications | Recommended Dilution |
| IHC | 1:50-1:200 |
Background
This gene encodes a type I transmembrane glycoprotein that is an integral component of the multimeric gamma-secretase complex.The encoded protein cleaves integral membrane proteins, including Notch receptors and beta-amyloid precursor protein, and may be a stabilizing cofactor required for gamma-secretase complex assembly.